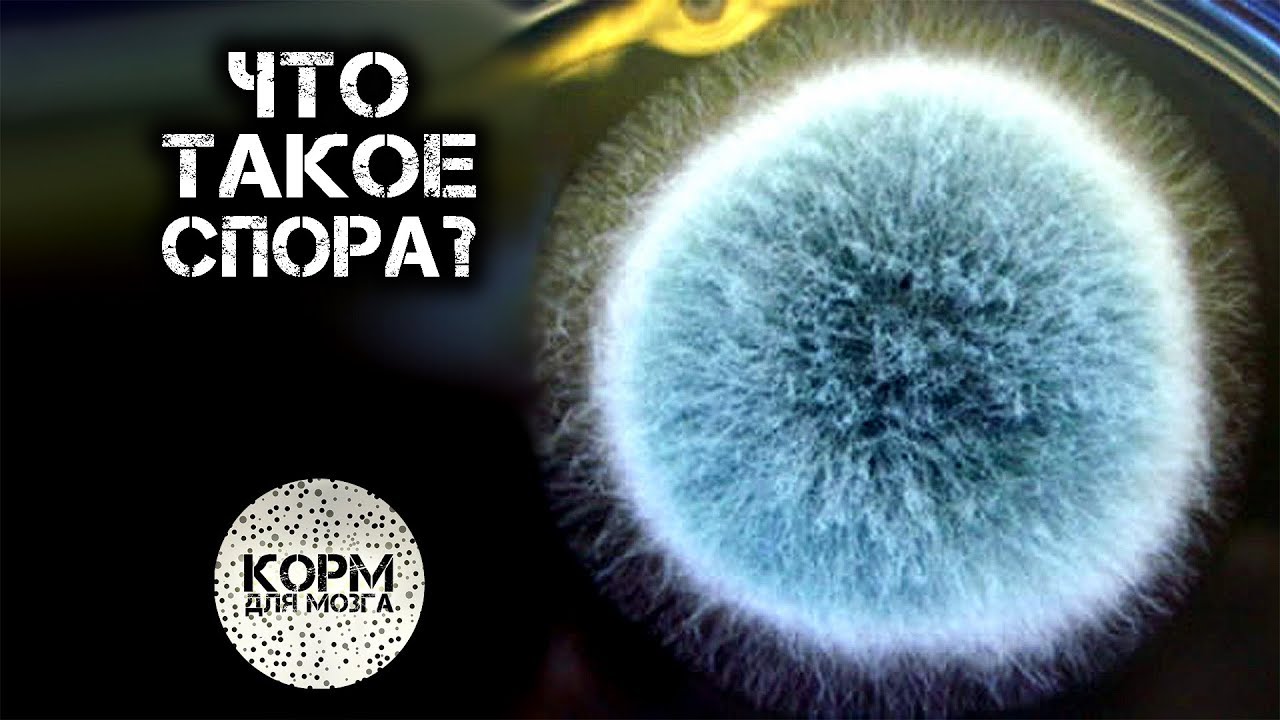

Споры представляют собой
Квартира приобретена до брака в ипотеку
Lenovo slim 14
Гнездышко по составу разобрать 4 класс
Как вывести пятна от пота на одежде
Сценарии спортивного для детского сада
Вебке видеочат
Ярмарка август пермь
Подкрылки передних колес
Что есть еще алиса
Крючок коврики видео
Что вкусное приготовить из огурцов
Найти видео владус
Убери урок
Споры представляют собой 75 фото